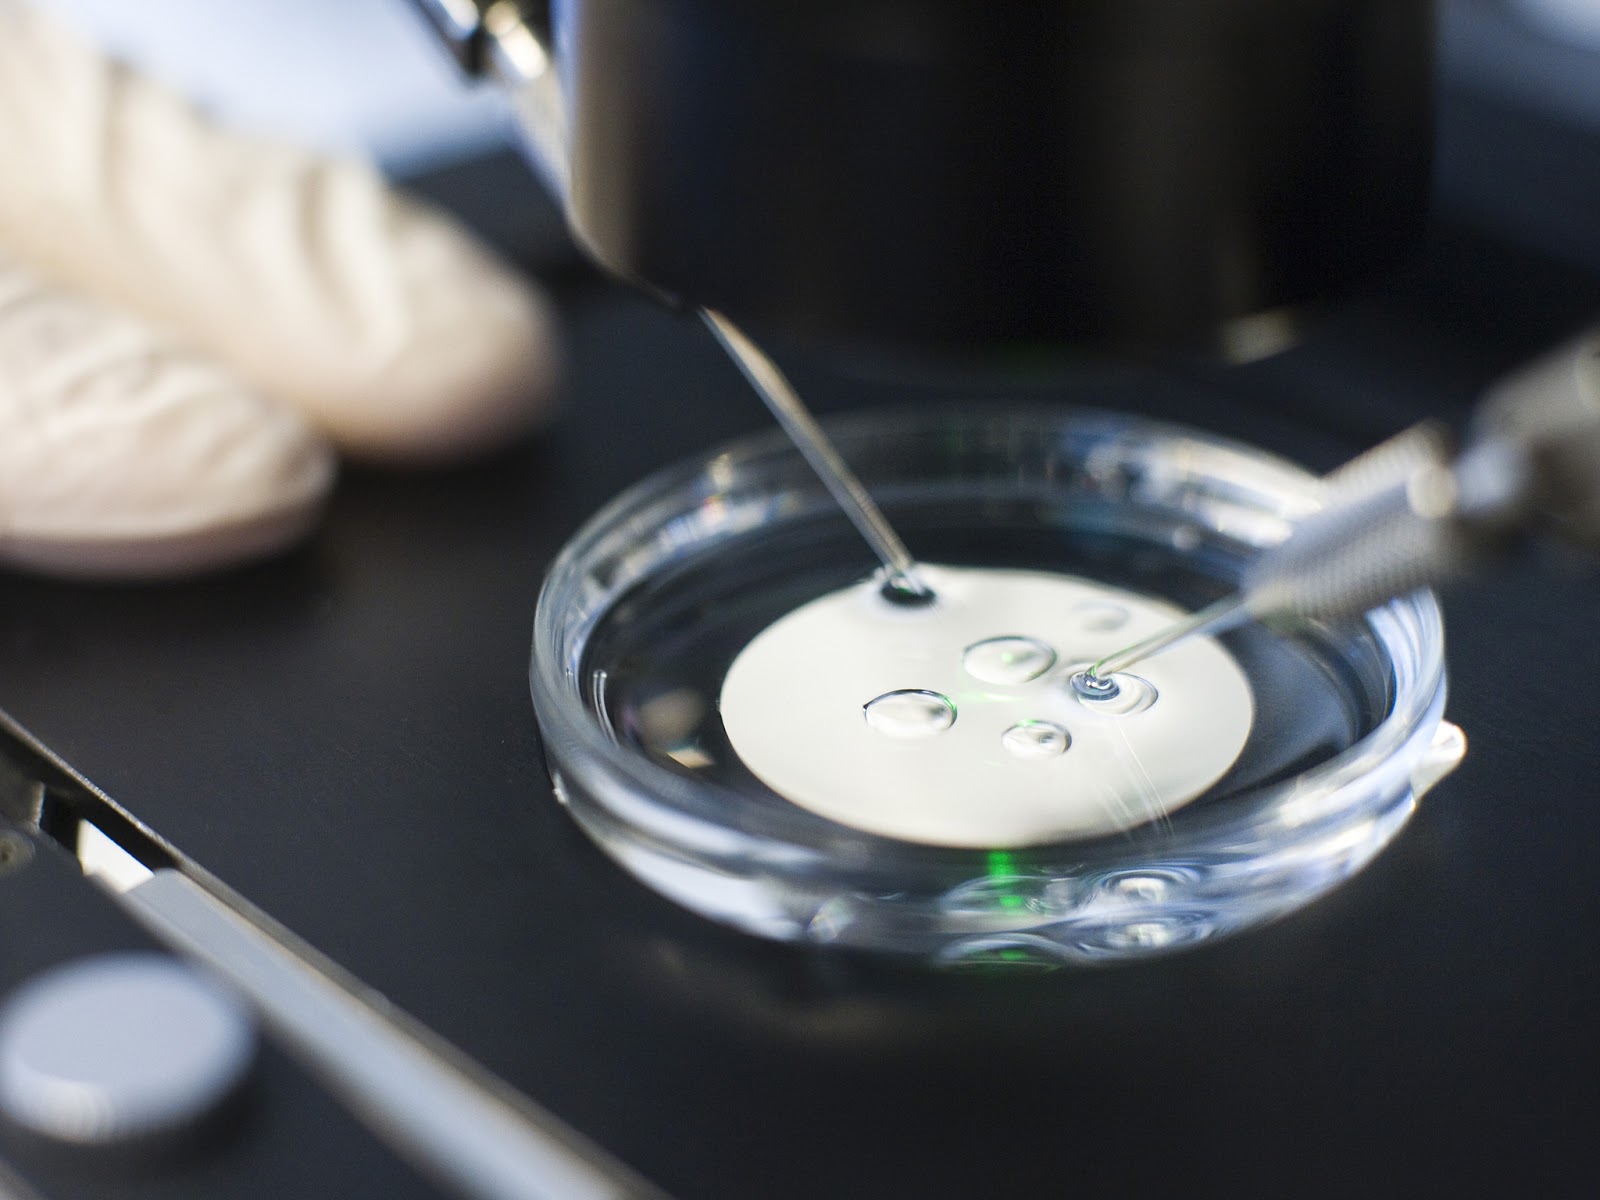
Глава 25а: Бебе в епруветка - IVF & GIFT

Стерилитет от А до Я
Преведената на български език книга за стерилитета на д-р Малпани
Глава 27: Използване на донорска сперма
Публикувано на: 03.02.2013 ТЕРАПЕВТИЧНА ИНСЕМИНАЦИЯ ОТ ДОНОР (ТИД) означава използване на сперма от анонимен донор, за да се по...
ПовечеГлава 25г: Успеваемост при IVF, трансфер на бластоцити и опростяване на IVF
Публикувано на: 03.02.2013 Как да тълкуваме нивата на успеваемост при ин витро процедурите?Нива на успеваемост – Разгадав...
ПовечеГлава 25в: Как се провежда трансфера на ембриони?
Публикувано на: 03.02.2013 Транфер на ембриони Трансферът на ембриони най-често се прави амбулаторно. Анастезия не се изполв...
ПовечеГлава 25б: Бебета в епруветка – инвитро фертилизация (IVF) и интратубарен трансфер на гамети
Публикувано на: 03.02.2013 Как се извършва аспирацията на яйцеклетките? В днешно време събирането на яйцеклетките се извърш...
ПовечеГлава 24: Какво е вътрематочна инсеминация?
Публикувано на: 03.02.2013 Понякога природата има нужда да и се помогне, за да започне бременност и докторът може да направи то...
ПовечеГлава 52: Защо се страхуват жените от ин витро фертилизация (IVF)?
Публикувано на: 03.02.2013 Защо някои пациенти се страхуват от IVF?На всеки е известно, че IVF (ин витро оплождане) е най-ефект...
ПовечеГлава 55: Самоосеменяване
Публикувано на: 03.02.2013 Какво представлява самоосеменяването? Самоосеменяването, в духа на "направи си сам",...
ПовечеГлава 25а: Бебе в епруветка - IVF & GIFT
Публикувано на: 07.02.2012 Раждането на Луиз Браун чрез ин витро фертилизация (IVF) през 1978 г. беше огромен напредък в лечени...
ПовечеГлава 03: Да открием какво не е наред – Основните медицински изследвания
Публикувано на: 29.05.2010 Основни медицински изследвания, нужни, за да се оцени способността за зачеване За да разберем защо ...
ПовечеГлава 02: Зачеването
Публикувано на: 29.05.2010 Всеки ученик знае, че за зачеването на дете са нужни яйцеклетка и сперматозоид. Все пак ние ще разгл...
Повече